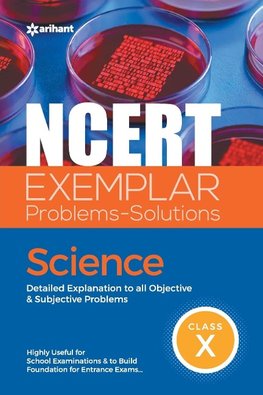
NCERT Exemplar Problems-Solutions Science class 10th

-
 Anglický jazyk
Anglický jazyk
NCERT Exemplar Problems-Solutions Science class 10th
Autor: Indu Gupta Sikha Sharma Rajesh Singh
Problem-solving is just like other skills we need to master in life. To be good at it, we need to practice it with the right approach. In view of this, DESM & NCERT has developed Exemplar Problems to provide a large number of quality problems. Get your hands... Viac o knihe
Na objednávku
41.52 €
bežná cena: 43.70 €
O knihe
Problem-solving is just like other skills we need to master in life. To be good at it, we need to practice it with the right approach. In view of this, DESM & NCERT has developed Exemplar Problems to provide a large number of quality problems. Get your hands on the latest edition of "NCERT EXEMPLAR PROBLEMS-SOLUTIONS: SCIENCE" which has been designed for class X students to master the basic technique of problem-solving. This book contains Explanatory & Accurate Solutions to all the questions given in the NCERT Exemplar Science book. Besides this, two additional features, that is, Thinking Process and Note have been included to enhance the learning and thinking abilities of students. Acquiring this book will be highly useful to score best in school examinations and build a foundation for entrance examinations. It offers: An all-inclusive book of NCERT Exemplar Problem-Solution Explanatory & accurate solutions to all questions A thinking process to tell how to solve a problem Notes are provided with special points A great tool to learn each concept of science in a complete manner TABLE OF CONTENT: Chemical Reactions and Equations, Acids, Bases and Salts, Metals and Non-metals, Carbon and Its compounds, Periodic Classification of Elements, Life Processes, Control and Coordination, How do Organisms Reproduce?, Heredity and Evolution, Light, Reflection and Refraction, Human Eye and Colourful World, Electricity, Magnetic Effects of Electric Current, Sources of Energy, Our Environment, Management of Natural Resources
- Vydavateľstvo: Arihant Publication India Limited
- Rok vydania: 2022
- Formát: Paperback
- Rozmer: 234 x 156 mm
- Jazyk: Anglický jazyk
- ISBN: 9789327197396




 Nemecký jazyk
Nemecký jazyk 







 Španielsky jazyk
Španielsky jazyk 